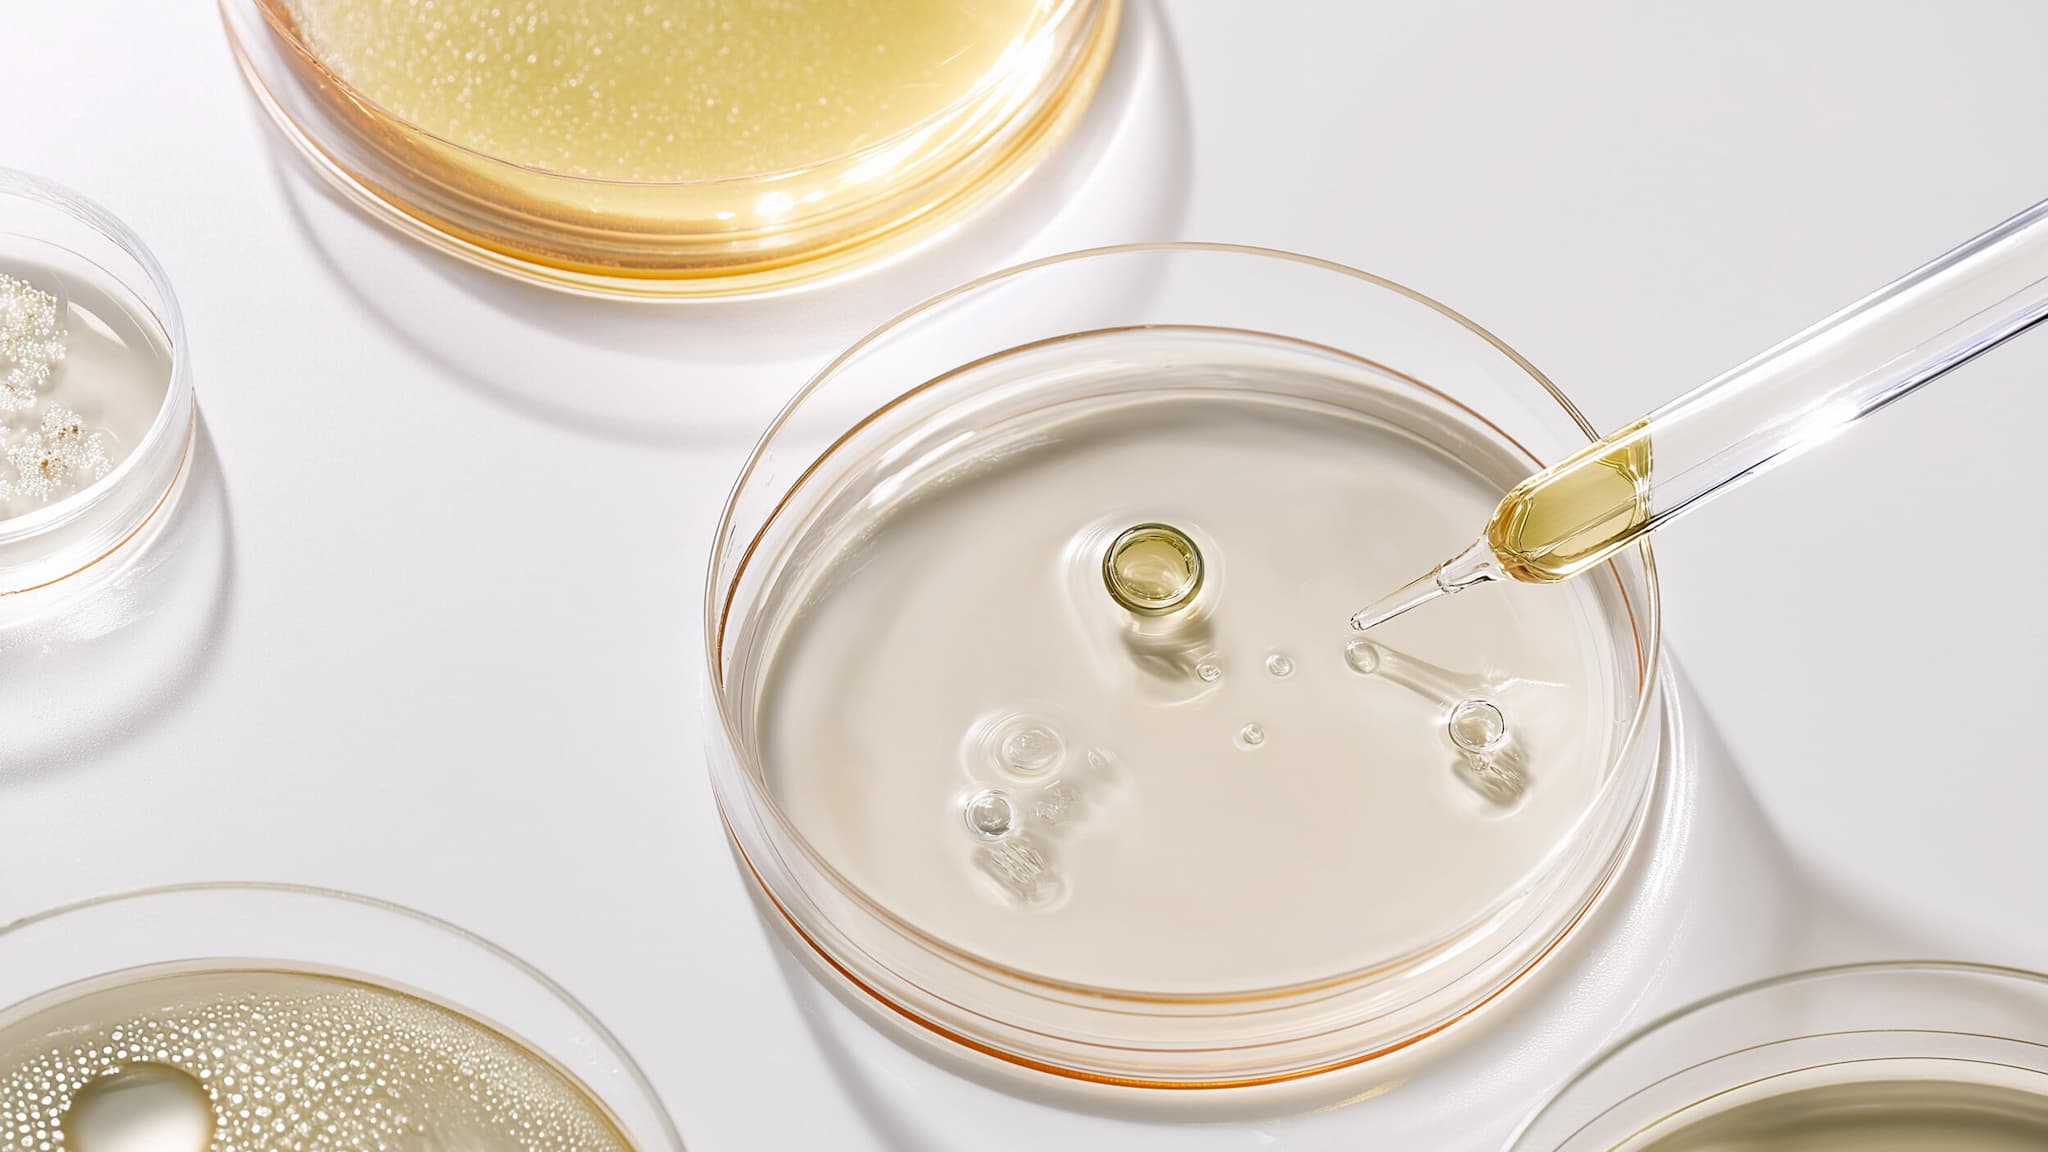
Draufsicht Petrischalen mit Flüssigkeiten und Pipette

Die Mikrobiomforschung hat in den letzten zehn Jahren enorme Fortschritte gemacht. Dank moderner Sequenzierungstechniken können heute selbst kleinste Veränderungen in der Bakterienvielfalt des Darms analysiert werden. Wissenschaftler entdecken dabei ständig neue Zusammenhänge zwischen Darmbakterien und Erkrankungen wie Depression, Diabetes, Adipositas oder Autoimmunerkrankungen.
Ein aktueller Forschungstrend ist die sogenannte „Metagenomik“. Dabei wird nicht nur untersucht, welche Bakterien vorhanden sind, sondern auch welche Funktionen sie erfüllen – also welche Gene aktiv sind. So lassen sich Rückschlüsse auf Entzündungsneigung, Immunreaktionen oder Nährstoffverwertung ziehen.
Auch die Rolle des Mikrobioms bei Krebsimmuntherapien wird intensiv erforscht: Erste Studien zeigen, dass der Erfolg bestimmter Therapien vom Zustand des Darms abhängig ist.